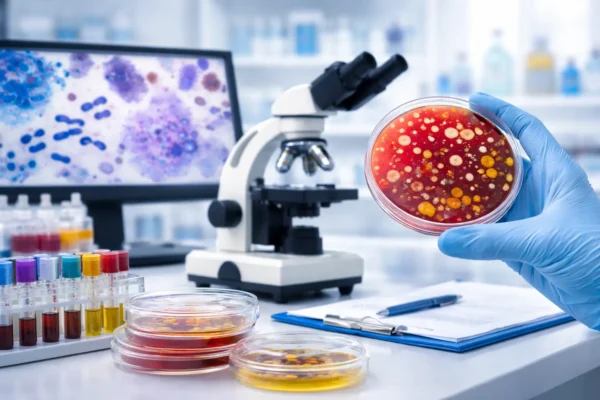
microbiology

Microbiology
Microbiology processing is done on fully automated equipment like Bact/ALERT 3D & VITEK 2 Compact 60 with a much faster turn around time. It includes:
1) Bacteriology: VITEK 2 compact 60 BacT/ALERT 3D for identification and MIC of around >2000 organisms and conventional microbiology diagnostic tools Gram stain, capsular stain, special stains.
Samples: blood, urine, stool, sputum, pus, CSF, other body fluids, tissue, and miscelleneous aerobic cultures, anaerobic cultures, blood cultures, Anti-microbial susceptibility testing by MIC method, Anti-microbial testing by kirbey-beur disk diffusion method. We follow the Latest CLSI, EUCAST, and BSAC standards for reliable and trustworthy results.
2) Mycobacteriology: Technology used MGIT Genotype MTBDR plus GeneXpert Conventional LJ cultures TB PCR TB gold LED microscopy ZN staining
Samples: skin scrappings, nail clippings, hair, blood, urine, stool, pus, CSF, other body fluids,tissue, miscelleneous yeast dermatophytes, dematitious fungi, systemic fungal infections, MIC values for Antifungal susceptibility testing of yeast. Latest CLSI standards followed.
3) Mycology: BacT/ALERT 3D, VITEK 2 compact 60 for identification and MIC of yeasts and conventional microbiology diagnostic tools KOH mount INDIA INK for capsulated organism Slide cultures Special fungal stain
Samples: Sputum,BAL,tracheal aspirate,Pus,FNAC lymphnode,tissue,body fluids,miscellaneous.
Mycobacterial cultures Drug sensitivity for primary line and secondary line of ATT. WHO, RNTCP references used for Microscopy reporting.
4) Parasitology : Microscopy, rapid immunochromatographic assays & immunoassays on blood, urine, stool & miscellaneous samples.
